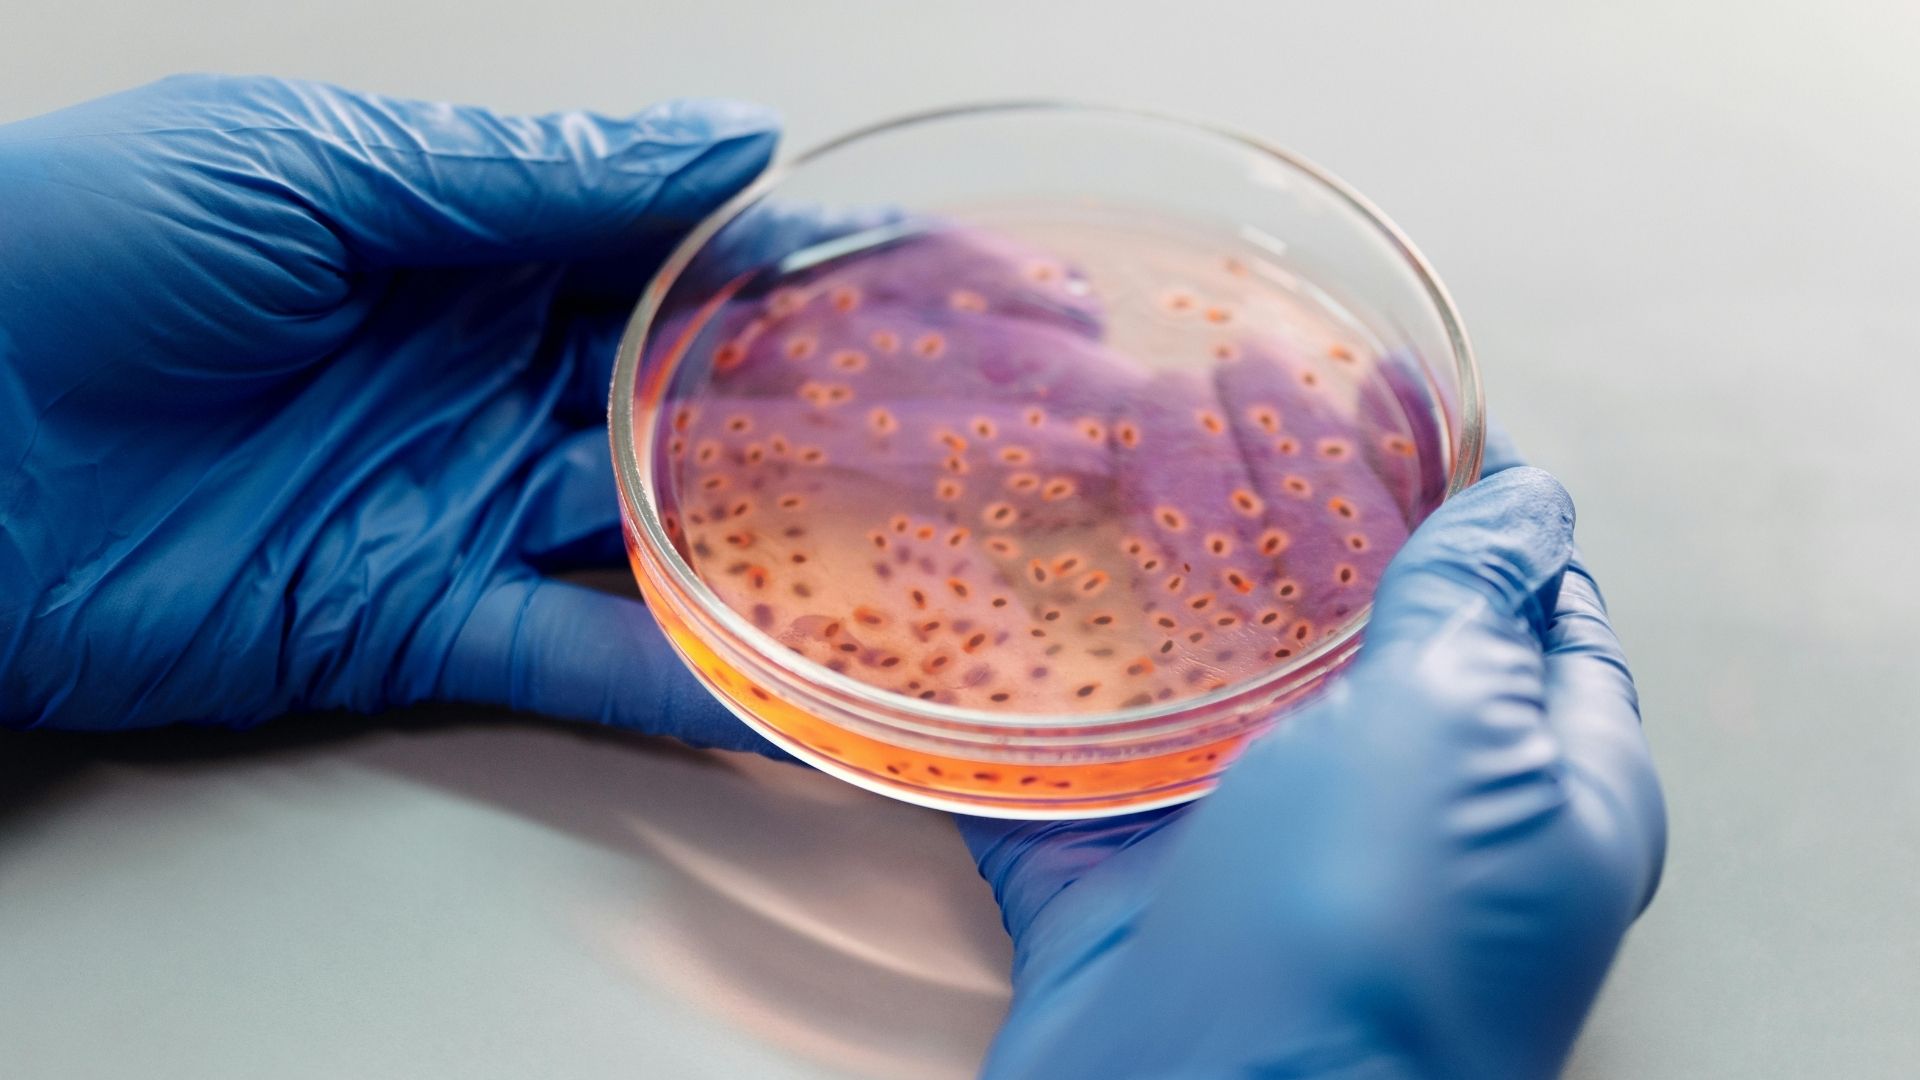
Chứng đau khi xuất tinh có thể gây ra do nhiễm trùng đường tiểu

Tìm hiểu chung về đau khi xuất tinh
Đau khi xuất tinh (thuật ngữ y khoa là Dysorgasmia hoặc Odynorgasmia) được định nghĩa là cảm giác đau đớn khó chịu xuất hiện tại cơ quan sinh dục, vùng chậu hoặc vùng hậu môn trong hoặc ngay sau khi phóng tinh.
Cơ chế gây đau thường liên quan đến sự co thắt bất thường của các cơ vùng chậu, tình trạng viêm nhiễm gây phù nề niêm mạc đường dẫn tinh hoặc sự tắc nghẽn ống phóng tinh. Cảm giác đau có thể làm giảm ham muốn tình dục, gây lo âu và thậm chí dẫn đến rối loạn cương dương thứ phát do tâm lý sợ đau.
Triệu chứng đau khi xuất tinh
Những dấu hiệu và triệu chứng của đau khi xuất tinh
Triệu chứng đau khi xuất tinh có thể biểu hiện rất đa dạng tùy thuộc vào nguyên nhân gốc rễ và ngưỡng chịu đau của từng người bệnh. Dưới đây là những đặc điểm lâm sàng thường gặp mà nam giới cần lưu ý:
- Vị trí đau: Cơn đau thường khu trú ở đầu dương vật, dọc theo niệu đạo, vùng bìu, vùng tầng sinh môn (khoảng giữa bìu và hậu môn) hoặc lan ra vùng bụng dưới.
- Tính chất cơn đau: Người bệnh có thể cảm thấy đau nhói như kim châm, đau buốt rát như bị bỏng hoặc đau âm ỉ kéo dài sâu bên trong vùng chậu.
- Thời điểm xuất hiện: Đa số trường hợp cơn đau xảy ra ngay tại thời điểm xuất tinh nhưng cũng có thể kéo dài vài phút đến vài giờ (thậm chí 24 giờ) sau khi quan hệ.

Biến chứng có thể gặp khi mắc chứng đau khi xuất tinh
Nếu không được can thiệp điều trị kịp thời, tình trạng này có thể dẫn đến những hệ lụy tiêu cực về cả sức khỏe thể chất lẫn tinh thần:
- Suy giảm chức năng tình dục: Cảm giác đau đớn khiến nam giới sợ hãi việc quan hệ, dẫn đến giảm ham muốn (libido) và né tránh bạn tình.
- Rối loạn cương dương: Tâm lý căng thẳng và lo âu về cơn đau sắp tới có thể ức chế cơ chế cương cứng tự nhiên của dương vật.
- Vô sinh hiếm muộn: Nếu nguyên nhân gây đau là do tắc nghẽn ống phóng tinh hoặc viêm nhiễm mãn tính thì chất lượng và số lượng tinh trùng có thể bị ảnh hưởng nghiêm trọng.

Khi nào cần gặp bác sĩ?
Nam giới không nên âm thầm chịu đựng hoặc tự ý mua thuốc điều trị khi gặp các vấn đề về xuất tinh. Bạn cần đến các cơ sở y tế có chuyên khoa Nam học hoặc Tiết niệu ngay khi nhận thấy các dấu hiệu sau:
- Cảm giác đau khi xuất tinh lặp lại nhiều lần và không có dấu hiệu thuyên giảm.
- Quan sát thấy tinh dịch có lẫn máu hoặc mủ.
- Đau kèm theo sốt cao, rét run hoặc tiểu khó (dấu hiệu của nhiễm trùng cấp tính).
- Có tiền sử chấn thương vùng chậu hoặc vừa trải qua phẫu thuật đường tiết niệu.
Nguyên nhân gây đau khi xuất tinh
Các nguyên nhân gây bệnh rất phức tạp và thường được Bác sĩ chuyên khoa chia thành các nhóm chính sau để thuận tiện cho việc chẩn đoán:
- Bệnh lý tuyến tiền liệt: Đây là nguyên nhân phổ biến nhất, bao gồm viêm tuyến tiền liệt cấp và mãn tính (Chronic Prostatitis), phì đại lành tính tuyến tiền liệt (BPH) hoặc ung thư tuyến tiền liệt.
- Nhiễm trùng đường tiết niệu - sinh dục: Các bệnh lây truyền qua đường tình dục như lậu, Chlamydia hoặc nhiễm trùng niệu đạo do vi khuẩn đường ruột có thể gây viêm và đau buốt.
- Tác dụng phụ của thuốc: Một số loại thuốc chống trầm cảm (đặc biệt là nhóm ức chế tái hấp thu chọn lọc Serotonin - SSRI và thuốc chống trầm cảm ba vòng) có thể gây rối loạn chức năng xuất tinh và gây đau.
- Tổn thương thần kinh: Bệnh đái tháo đường biến chứng thần kinh hoặc tổn thương tủy sống có thể làm rối loạn dẫn truyền cảm giác và gây đau.
- Vấn đề sau phẫu thuật: Các can thiệp ngoại khoa như phẫu thuật cắt bỏ tuyến tiền liệt, phẫu thuật thoát vị bẹn có thể để lại di chứng đau đớn.
- Yếu tố tâm lý: Căng thẳng, lo âu quá mức hoặc các vấn đề trong mối quan hệ cũng có thể biểu hiện thành triệu chứng đau thực thể.
Nguy cơ mắc phải đau khi xuất tinh
Những ai có nguy cơ mắc chứng đau khi xuất tinh?
Tình trạng này có thể xảy ra ở nam giới trong mọi độ tuổi hoạt động tình dục nhưng phổ biến hơn ở một số nhóm đối tượng cụ thể:
- Nam giới trung niên và cao tuổi: Nhóm này có nguy cơ cao mắc các bệnh lý về tuyến tiền liệt như phì đại hoặc viêm nhiễm mãn tính.
- Người đang điều trị tâm lý: Những bệnh nhân đang sử dụng thuốc chống trầm cảm hoặc thuốc an thần dài ngày.
- Người có đời sống tình dục không an toàn: Nhóm đối tượng có nhiều bạn tình và không sử dụng biện pháp bảo vệ dễ mắc các bệnh nhiễm trùng đường sinh dục.
Yếu tố làm tăng nguy cơ mắc chứng đau khi xuất tinh
Một số yếu tố lối sống và sức khỏe có thể thúc đẩy sự xuất hiện hoặc làm trầm trọng thêm tình trạng bệnh:
- Tiền sử nhiễm trùng: Người từng bị viêm tinh hoàn, viêm mào tinh hoàn hoặc nhiễm trùng tiết niệu tái đi tái lại.
- Dị tật bẩm sinh: Các bất thường về cấu trúc đường tiết niệu như hẹp niệu đạo hay nang túi tinh.
- Căng thẳng kéo dài: Stress mãn tính làm tăng trương lực cơ vùng chậu và gây co thắt đau đớn khi phóng tinh.

Phương pháp chẩn đoán và điều trị đau khi xuất tinh
Phương pháp xét nghiệm và chẩn đoán đau khi xuất tinh
Để xác định chính xác nguyên nhân, Bác sĩ chuyên khoa sẽ tiến hành thăm khám lâm sàng kỹ lưỡng và chỉ định các xét nghiệm cận lâm sàng cần thiết:
- Thăm khám trực tràng (DRE): Bác sĩ kiểm tra tuyến tiền liệt qua đường hậu môn để đánh giá kích thước, độ cứng và mức độ đau của tuyến.
- Xét nghiệm nước tiểu và tinh dịch đồ: Nhằm tìm kiếm sự hiện diện của bạch cầu, hồng cầu hoặc vi khuẩn gây bệnh.
- Xét nghiệm sàng lọc STI: Kiểm tra các bệnh lây truyền qua đường tình dục như lậu, Chlamydia, Trichomonas.
- Siêu âm hệ tiết niệu: Siêu âm qua trực tràng hoặc qua đường bụng để quan sát hình ảnh tuyến tiền liệt, túi tinh và bàng quang.
- Xét nghiệm PSA: Đo kháng nguyên đặc hiệu tuyến tiền liệt trong máu để sàng lọc nguy cơ ung thư ở nam giới lớn tuổi.
Phương pháp điều trị đau khi xuất tinh
Chiến lược điều trị phụ thuộc hoàn toàn vào nguyên nhân gốc rễ được tìm thấy. Bác sĩ chuyên khoa sẽ xây dựng phác đồ cá nhân hóa cho từng bệnh nhân:
- Điều trị nội khoa bằng kháng sinh: Nếu nguyên nhân là do nhiễm khuẩn (viêm tuyến tiền liệt, viêm niệu đạo), bệnh nhân sẽ được kê đơn kháng sinh phù hợp như Ciprofloxacin, Levofloxacin hoặc Doxycycline trong thời gian từ 2 đến 4 tuần.
- Thuốc chẹn Alpha: Các thuốc như Tamsulosin, Alfuzosin giúp làm giãn cơ trơn tại cổ bàng quang và tuyến tiền liệt, từ đó giảm áp lực và giảm đau khi xuất tinh.
- Điều chỉnh thuốc đang sử dụng: Nếu nghi ngờ thuốc chống trầm cảm là nguyên nhân, bác sĩ có thể giảm liều hoặc chuyển sang loại thuốc khác ít tác dụng phụ hơn.
- Liệu pháp tâm lý và tình dục: Tư vấn tâm lý giúp giải quyết các lo âu, căng thẳng và hướng dẫn các bài tập thư giãn cơ sàn chậu (như bài tập Kegel).
Chế độ sinh hoạt và phòng ngừa đau khi xuất tinh
Những thói quen sinh hoạt có thể giúp bạn hạn chế diễn tiến của đau khi xuất tinh
Chế độ sinh hoạt:
Việc thay đổi lối sống đóng vai trò quan trọng trong việc hỗ trợ điều trị và ngăn ngừa cơn đau tái phát, cụ thể:
- Duy trì hoạt động tình dục điều độ: Không kìm nén xuất tinh nhưng cũng tránh quan hệ quá độ gây sung huyết vùng chậu.
- Ngâm nước ấm: Ngâm mình trong bồn nước ấm khoảng 15 đến 20 phút mỗi ngày giúp thư giãn cơ vùng chậu và giảm đau hiệu quả.
- Tránh ngồi quá lâu: Nếu làm việc văn phòng hoặc lái xe, hãy đứng dậy đi lại sau mỗi giờ để giảm áp lực lên tuyến tiền liệt.
Chế độ dinh dưỡng:
Bên cạnh chế độ sinh hoạt, người mắc chứng đau khi xuất tinh cần chú ý đến chế độ dinh dưỡng gồm:
- Uống đủ nước: Đảm bảo uống từ 2 lít nước mỗi ngày để tăng cường đào thải vi khuẩn ra khỏi đường tiết niệu.
- Hạn chế chất kích thích: Tránh xa rượu bia, cà phê và thức ăn cay nóng vì chúng có thể gây kích ứng bàng quang và tuyến tiền liệt.
- Tăng cường thực phẩm giàu kẽm: Bổ sung hải sản, hạt bí ngô, thịt bò giúp tăng cường sức đề kháng cho tuyến tiền liệt.

Phương pháp phòng ngừa đau khi xuất tinh
Nam giới hoàn toàn có thể giảm thiểu nguy cơ mắc chứng đau khi xuất tinh bằng các biện pháp dự phòng tích cực.
- Thực hành tình dục an toàn: Sử dụng bao cao su trong mọi lần quan hệ để ngăn ngừa các bệnh lây truyền qua đường tình dục (nguyên nhân hàng đầu gây viêm nhiễm đường sinh dục).
- Vệ sinh vùng kín sạch sẽ: Rửa sạch bộ phận sinh dục hàng ngày, đặc biệt là trước và sau khi quan hệ tình dục để ngăn chặn vi khuẩn xâm nhập ngược dòng.
- Không nhịn tiểu: Đi tiểu ngay khi có nhu cầu và sau khi xuất tinh để giúp làm sạch niệu đạo và tống xuất vi khuẩn.
- Kiểm tra sức khỏe định kỳ: Nam giới trên 40 tuổi hoặc có các triệu chứng rối loạn tiểu tiện nên đi khám Nam khoa định kỳ để tầm soát sớm các bệnh lý tuyến tiền liệt.

Đau khi xuất tinh không phải là dấu chấm hết cho đời sống tình dục mà là tín hiệu cơ thể đang cần được chăm sóc y tế. Với sự tiến bộ của y học hiện đại, hầu hết các trường hợp đều có thể được điều trị thành công nếu được chẩn đoán đúng nguyên nhân. Nam giới hãy chủ động chia sẻ với Bác sĩ chuyên khoa để nhận được sự tư vấn và phác đồ điều trị tối ưu nhất, giúp duy trì phong độ và hạnh phúc lứa đôi.
:format(webp)/470051785_8767135473405056_691967411107495592_n_6b2bbff755.png)
:format(webp)/467434554_545745841560409_1066418224364723785_n_560a494f9c.png)
:format(webp)/benh_a_z_dau_khi_xuat_tinh_d014b4ce28.jpg)
/bi_da_vao_tinh_hoan_co_sao_khong_dieu_nam_gioi_can_luu_y_2_9e68a201c6.png)
/dau_tinh_hoan_ac71bd6b7c.jpeg)
/ung_thu_tinh_hoan_1efdb3b9e1.jpeg)
/xoan_tinh_hoan1_b16bc93bac.jpg)
/tran_dich_mang_tinh_hoan_f271fec8aa.jpeg)